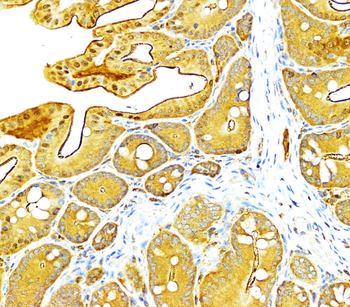
VEGF Antibody
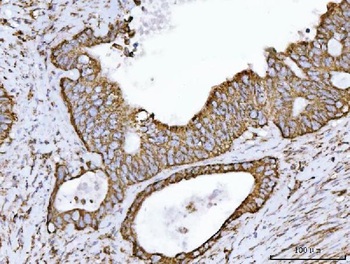
ECHS1 Antibody
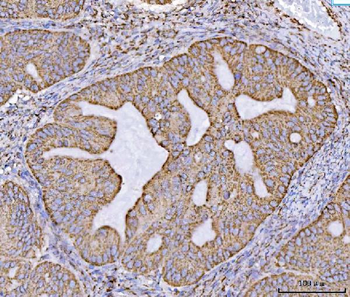
ECHS1 Antibody

You have no items in your shopping cart.
VEGF antibody
Description
Images & Validation
−| Tested Applications | ELISA, ICC, IF, IHC-P, WB |
|---|---|
| Dilution range | IF/ICC:1:100, IHC-P: 1:50, WB: 1:200 |
| Reactivity | Bovine, Canine, Gallus, Guinea pig, Human, Mouse, Porcine, Rat, Sheep |
Key Properties
−| Host | Rabbit |
|---|---|
| Clonality | Polyclonal |
| Isotype | IgG |
| Immunogen | KLH conjugated synthetic peptide derived from human VEGF. Please contact us for the exact immunogen sequence. The peptide is available as orb374829. |
| Target | VEGF |
| Purity | Polyclonal antibodies are purified by peptide affinity chromatography |
| Conjugation | Unconjugated |
Storage & Handling
−| Storage | Maintain refrigerated at 2-8°C for up to 2 weeks. For long term storage store at -20°C in small aliquots to prevent freeze-thaw cycles. |
|---|---|
| Form/Appearance | 10 mM PBS, 0.02% sodium azide, 10mg/ml rAlbumin, 25% glycerol |
| Concentration | - 100 μg (in 200 μl): 0.5 mg/ml- 200 μg (in 400 μl): 0.5 mg/ml |
| Disclaimer | For research use only |
Alternative Names
−Similar Products
−SNRNP200 Antibody [orb1474824]
ELISA, FC, ICC, IF, IHC, WB
Human, Mouse, Rat
Rabbit
Polyclonal
Unconjugated
100 μgECHS1 Antibody [orb1173494]
ELISA, FC, ICC, IF, IHC, WB
Human, Mouse, Rat
Rabbit
Polyclonal
Unconjugated
100 μgNeuropilin-1 Recombinant Rabbit Monoclonal Antibody [orb608055]
IF, IHC-Fr, IHC-P, WB
Mouse, Rat
Human, Mouse, Rat
Rabbit
Recombinant
Unconjugated
50 μl, 100 μl

Quality Guarantee
Explore bioreagents carefree to elevate your research. All our products are rigorously tested for performance. If a product does not perform as described on its datasheet, our scientific support team will provide expert troubleshooting, a prompt replacement, or a refund. For full details, please see our Terms & Conditions and Buying Guide. Contact us at support@biorbyt.com.

Western blot analysis of rat brain tissue using VEGFA antibody (dilution of primary antibody - 1:200)

IHC-P image of mouse skin tissue using anti-VEGFA (dilution of primary antibody at 1:50)

Immunofluorescence analysis of mouse skin tissue using VEGFA antibody (dilution of primary antibody - 1:100)

IHC-P staining of pig large intestines tissue using VEGFA antibody (dilution at 1:50)

IHC-P staining of mouse skin tissue using anti-VEGFA (dilution at 1:50)

IHC-P image of mouse kidney tissue using VEGFA antibody (dilution of primary antibody at 1:50)

IHC-P staining of pig kidney tissue using VEGFA antibody (dilution at 1:50)

Immunohistochemical staining of paraffin embedded mouse kidney tissue using anti-VEGFA (primary antibody at 1:50)

IF image of pig kidney tissue using VEGFA antibody (primary antibody at 1:100)

Immunohistochemical staining of paraffin embedded mouse skin tissue using anti-VEGFA (primary antibody at 1:50)
Quick Database Links
Documents Download
Request a Document
Protocol Information
Filter by Applications
Filter by Species
Pilmane, Mara et al. Singer's Nodules: Investigating the Etiopathogenetic Markers Progressing Their Pathogenesis and Clinical Manifestations Biology (Basel), 10, 1268 (2021)
Applications
Reactivity
Eduardo Quintão Manhanini Souza # 1, Luan Felipe Toro # 2 3, Vinícius Franzão Ganzaroli 1, Jéssica de Oliveira Alvarenga Freire 2 3, Mariza Akemi Matsumoto 2, Cláudio Aparecido Casatti 2, Luciano Tavares Ângelo Cintra 4, Rogério Leone Buchaim 5, João Paulo Mardegan Issa 6, Valdir Gouveia Garcia 7, Leticia Helena Theodoro 1, Edilson Ervolino Peri-implantitis increases the risk of medication-related osteonecrosis of the jaws associated with osseointegrated implants in rats treated with zoledronate Sci Rep, 14, 627. (2024)
Applications
Reactivity
K Dambergs Characterisation of Acquired Human Cholesteatoma in Ontogenetic Aspect rsu.lv, (2024)
Kristaps Dambergs 1 2, Gunta Sumeraga 1, Māra Pilmane Comparison of Tissue Factors in the Ontogenetic Aspects of Human Cholesteatoma Diagnostics (Basel), (2024)
Applications
Reactivity
K Dambergs Characterisation of Acquired Human Cholesteatoma in Ontogenetic Aspect. Summary of the Doctoral Thesis dspace.rsu.lv, (2024)
Juliano Milanezi de Almeida 1 2, Halef Diego Turini 1, Henrique Rinaldi Matheus 1 2 3, Otávio Augusto Pacheco Vitória 1 2, Bianca Rafaeli Piovezan 1 2, Ruan Henrique Barra Dalmonica 1 2, Elisa Mara de Abreu Furquim 1 2, Edilson Ervolino Omega-3 attenuates the severity of medication-related osteonecrosis of the jaws in rats treated with zoledronate PLoS One, (2025)
Alexandre Henrique Dos Reis-Prado 1, Isabela Joane Prado Silva 2, Juliana Goto 2, Nathália Evelyn da Silva Machado 2, Gleide Fernandes de Avelar 3, Juliano Douglas Silva Albergaria 3, Raphael Escorsim Szawka 4, Marco Cícero Bottino 5, Luciano Tavares Angelo Cintra 2, Edilson Ervolino 6, Antônio Paulino Ribeiro-Sobrinho 1, Francine Benetti EDTA enhances cementum-like tissue formation, TGF-β1 & VEGF in rat molars during regenerative endodontics Braz Oral Res ., (2025)
Applications
Reactivity
Dambergs, Kristaps et al. Morphopathogenesis of Adult Acquired Cholesteatoma Medicina (Kaunas), 59, 306 (2023)
Applications
Reactivity
K, Dambergs et al. Complex Evaluation of Tissue Factors in Pediatric Cholesteatoma Children (Basel, Switzerland), 8, (2021)
Applications
Reactivity
VEGF antibody (orb191500)
Participating in our Biorbyt product reviews program enables you to support fellow scientists by sharing your firsthand experience with our products.
Login to Submit a Review